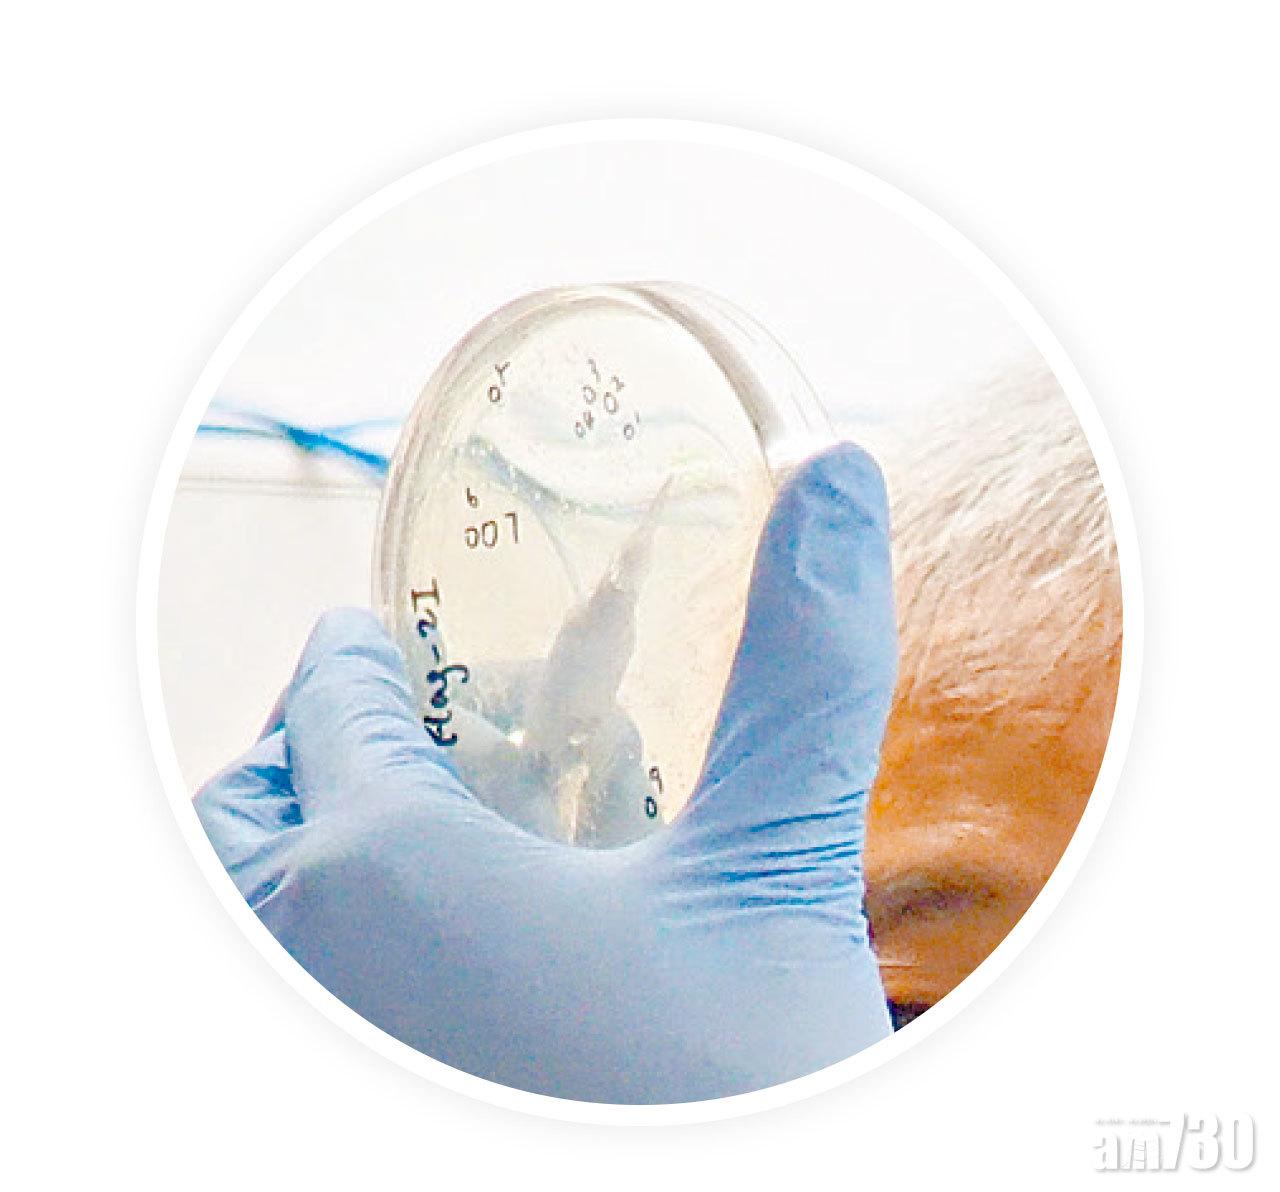

科大最近研發出「突觸後緻密區」的蛋白重構技術。

自閉症、精神分裂症等精神障礙,已知是由於神經細胞中負責訊號傳遞的突觸(synapse)蛋白突變所致,但科學界對突觸的組成和運作機制所知不多;科大最近發表突破性的生物化學重構技術,成功在體外重塑出「突觸後緻密區」的蛋白結構,相信長遠有助更全面理解大腦運作,今後或能為精神障礙作早期診治。
人類腦部的神經元由細小功能單元「突觸」相互連接,而每個突觸均有一個稱為「突觸後致密區」的細胞區室,載有大量並且密集排列的蛋白質層,負責處理及傳遞由腦部發出的訊號,若有關蛋白質變異,協調失敗,便會令腦部不能正常運作,出現精神障礙。但由於腦部有大量的突觸,而每個「突觸後致密區」的蛋白結構各異,因此一直以來的研究工作非常困難。
科大嘉里理學教授張明傑的研究團隊,最近研發出「突觸後緻密區」的蛋白重構技術,利用不同的蛋白質組合在體外重構成突觸,對於理解突觸與精神障礙的關係有莫大的幫助。


張明傑(左)及團隊於實驗室內觀察突觸蛋白的相互結合模式。(張逸羲攝)
張明傑指,以往的研究均利用「減法」處理,觀察突觸缺乏某一種蛋白質時對腦部的影響,惟做法較為單一;新技術則能觀察突觸的蛋白組成、顯示各種蛋白質之間如何互相配合,能更全面理解突觸的運作。團隊亦發現蛋白質分子能進行高度動態的分子交換,而突觸後緻密區域亦可調節記憶。他指,現時研究屬於基礎階段,將來會進一步進行臨床研究,或有助更了解精神障礙的成因及治療方法。研究成果已於8月發表在《細胞》期刊,為2016年工作成果的另一大突破。

















